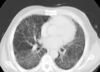

What is meant by restrictive lung disease?
Any disease in which there is a reduced ability of the lungs to expand to take in air
What are the 2 main categories of restrictive lung disease?
Intrinsic
Extrinsic
What is meant by intrinsic restrictive lung disease?
Any restrictive lung disease caused by a disease of the lung itself, most commonly the alveoli
What is meant by extrinsic restrictive lung disease?
Any restrictive lung disease caused by a disease of the structures surrounding the lungs, which prevents expansion
How do intrinsic restrictive lung diseases affect O2 and CO2 exchange?
It affects the diffusion barrier and so can affect O2 intake, however, CO2 exchange will usually be unimpaired as exhalation is still normal, so CO2 is still blown off
What are some diseases that increase pressure on the thorax and so can cause extrinsic restrictive lung disease?
Obesity
Kyphoscoliosis
Ascites (Fluid in peritoneal cavity)
Diaphragmatic palsy
What are some ways in which diseases can cause extrinsic restrictive lung diseases?
Increased thoracic pressure
Reduction of thoracic muscle contraction
Pleural diseases affecting lung compliance
What are some diseases affecting thoracic muscle contraction that can lead to extrinsic restrictive lung disease?
Motor neurone disease
Myasthenia gravis
What are some diseases that can affect the pleura and thus cause extrinsic restrictive lung disease?
Diffuse pleural thickening
Mesothelioma
Large pleural effusions
What is the first line test performed in suspected restrictive lung disease?
Pulmonary function testing
What will be shown on pulmonary function testing (Spirometry) in restrictive lung disease?
A restrictive pattern:
Decreased FVC - Less air into lungs
Maintained FEV1 - Rate of contraction unaffected
Therefore FER > 80%
What is meant by DLCO?
Diffusion Capacity of the Lungs to CO
How is DLCO affected in those with restrictive lung disease?
It will be decreased below 80%
What are some conditions that can result in decreased DLCO?
Restrictive lung disease
Anaemia
Emphysema
Pulmonary oedema
Pulmonary embolism
Asthma
What PaO2 level shows type I respiratory failure?
PaO2 < 8Kpa
What pCO2 levels shows type II respiratory failure?
pCO2 > 6kPa
Which form of respiratory failure can be seen in restrictive lung disease?
Both type I or type II
What are some 2nd line tests that can be performed in restrictive lung disease?
Chest X-ray
CT scanning
Pleural ultrasound
Connective tissue screen
Vasculitis screen
What will be seen on blood testing in restrictive lung disease?
Polycythaemia from chronic hypoxia
What are some common symptoms of CO2 retention in restrictive lung disease?
Headaches
Confusion
Lethargy
What are some common clinical findings in restrictive lung disease?
Finger clubbing
Obesity
Kyphoscoliosis
Fibrotic crepitations
Signs of pleural effusion or ascites
Cyanosis
What are some common clinical signs of CO2 retention in restrictive lung disease?
Flushed skin
Bounding pulse
Rapid breathing
Premature heart beat
Muscle twitches
Flapping tremor
What are some lifestyle management techniques in restrictive lung disease?
Improved diet and exercise
Pulmonary rehabilitation
Weight loss
How is myasthenia graves pharmacologically treated in restrictive lung disease?
Pyridostigmine